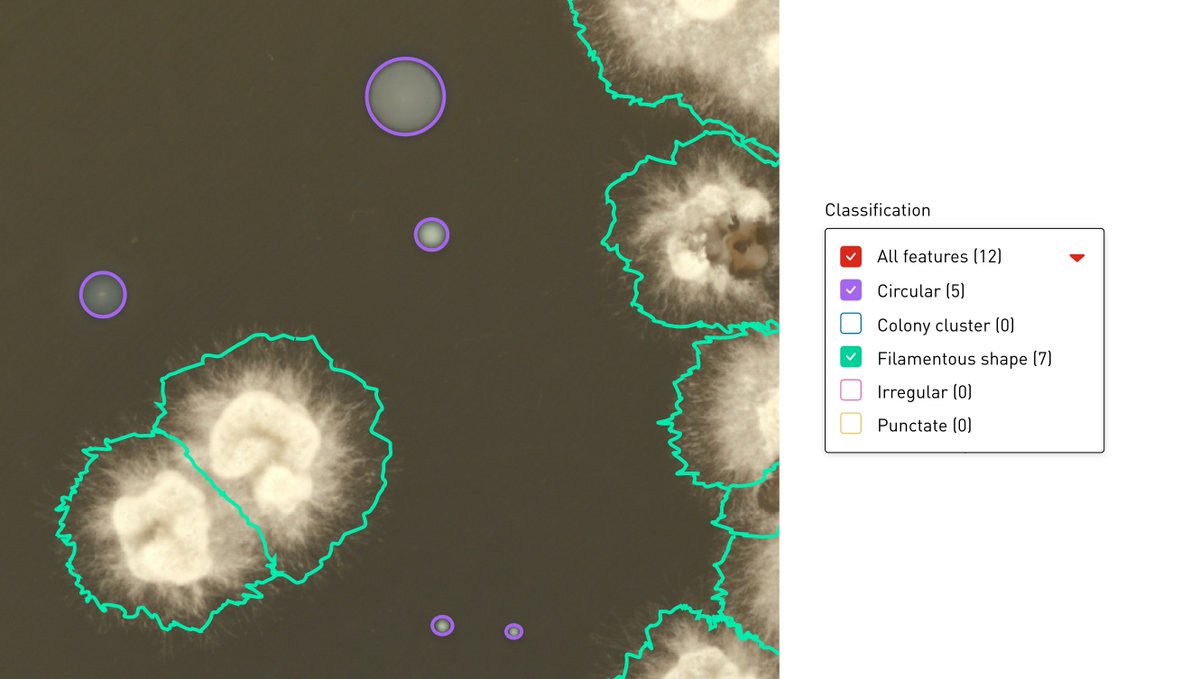
Singer Instruments tweet media

Sabitlenmiş Tweet

Introducing PIXL Max: our fastest automated colony picker yet with AI powered detection and analysis of both microbes and zones of inhibition. And super hi-res optics to detect the tiniest details of your colony morphologies. 🤖👩🔬
#LabAutomation #Microbiology

English